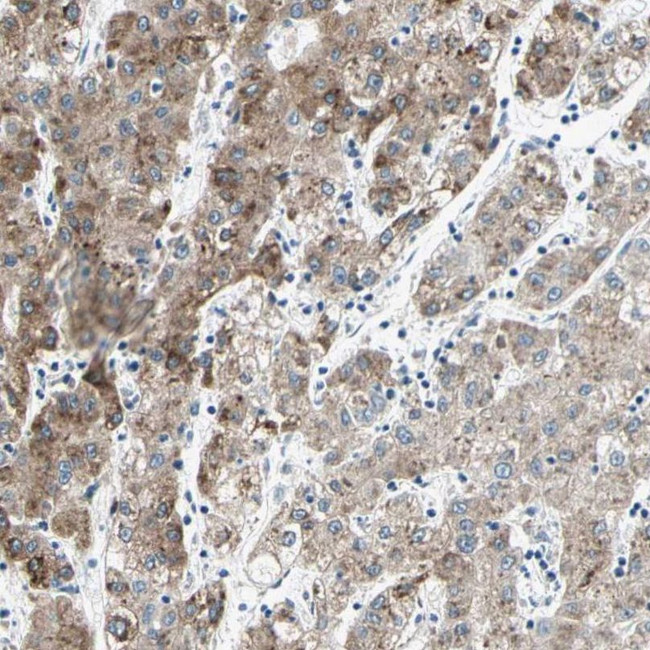
CYP2E1 Antibody in Immunohistochemistry (IHC)

Search
Invitrogen
CYP2E1 Polyclonal Antibody
{{$productOrderCtrl.translations['antibody.pdp.commerceCard.promotion.promotions']}}
{{$productOrderCtrl.translations['antibody.pdp.commerceCard.promotion.viewpromo']}}
{{$productOrderCtrl.translations['antibody.pdp.commerceCard.promotion.promocode']}}: {{promo.promoCode}} {{promo.promoTitle}} {{promo.promoDescription}}. {{$productOrderCtrl.translations['antibody.pdp.commerceCard.promotion.learnmore']}}
产品信息
PA5-52652
种属反应
已发表种属
宿主/亚型
分类
类型
抗原
偶联物
形式
浓度
规格
纯化类型
保存液
内含物
保存条件
运输条件
RRID
产品详细信息
Immunogen sequence: EKLHEEIDRV IGPSRIPAIK DRQEMPYMDA VVHEIQRFIT LVPSNLPHEA TRDTIFRGYL IPKGTVVVPT LDSVLYDNQE FPDPEKFKPE HFLNENGKFK YSDYFKPFST GKRVCAG
Highest antigen sequence identity to the following orthologs: Mouse - 86%, Rat - 86%.
靶标信息
This gene encodes a member of the cytochrome P450 superfamily of enzymes. The cytochrome P450 proteins are monooxygenases which catalyze many reactions involved in drug metabolism and synthesis of cholesterol, steroids and other lipids. This protein localizes to the endoplasmic reticulum and is induced by ethanol, the diabetic state, and starvation. The enzyme metabolizes both endogenous substrates, such as ethanol, acetone, and acetal, as well as exogenous substrates including benzene, carbon tetrachloride, ethylene glycol, and nitrosamines which are premutagens found in cigarette smoke. Due to its many substrates, this enzyme may be involved in such varied processes as gluconeogenesis, hepatic cirrhosis, diabetes, and cancer.
仅用于科研。不用于诊断过程。未经明确授权不得转售。
生物信息学
蛋白别名: 4-nitrophenol 2-hydroxylase; CP2E1; CYPIIE1; Cytochrome P450 2E1; cytochrome P450 subfamily 2e1 (ethanol-inducible); cytochrome P450, 2e1, ethanol inducible; cytochrome P450, family 2, subfamily E, polypeptide 1; cytochrome P450, subfamily 2E, polypeptide 1; cytochrome P450, subfamily IIE (ethanol-inducible), polypeptide 1; Cytochrome P450-ALC; Cytochrome P450-J; cytochrome P450A; cytochrome P450j; Cytochrome P450RLM6; flavoprotein-linked monooxygenase; microsomal monooxygenase; microsomal monooxygenase; xenobiotic monooxygenase; P450-J; P450RLM6; unnamed protein product; xenobiotic monooxygenase
基因别名: CPE1; CYP2E; Cyp2e-1; CYP2E1; P450-J; P450C2E
UniProt ID: (Human) P05181, (Mouse) Q05421, (Rat) P05182
Entrez Gene ID: (Human) 1571, (Mouse) 13106, (Rat) 25086